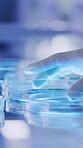
Medical, hands or person in lab with petri dish, biotechnology or bacteria test for vaccine development. Science, fluid exam or expert with sample plate, research or analysis in pharmaceutical study.
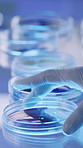
Medical, glass or hands in lab with petri dish, biotechnology or bacteria test for vaccine development. Fluid, examination or scientist with sample plate, research or analysis in pharmaceutical study
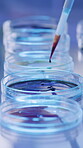
Medical, pipette or person in lab with petri dish, biotechnology or bacteria test for vaccine development. Science, fluid exam or expert with sample, research or analysis in pharmaceutical study.

Stock Photo - Face, research and black woman with microscope, science and forensic experiment in lab. Person, scientist and biology with equipment, medical test and dna results with particles analysis or smile
Face, research and black woman with microscope, science and forensic experiment in lab. Person, scientist and biology with equipment, medical test and dna results with particles analysis or smile - Stock Photo
Stock photo ID: 3352546
How do you plan to use this image?
Choose Size and Download